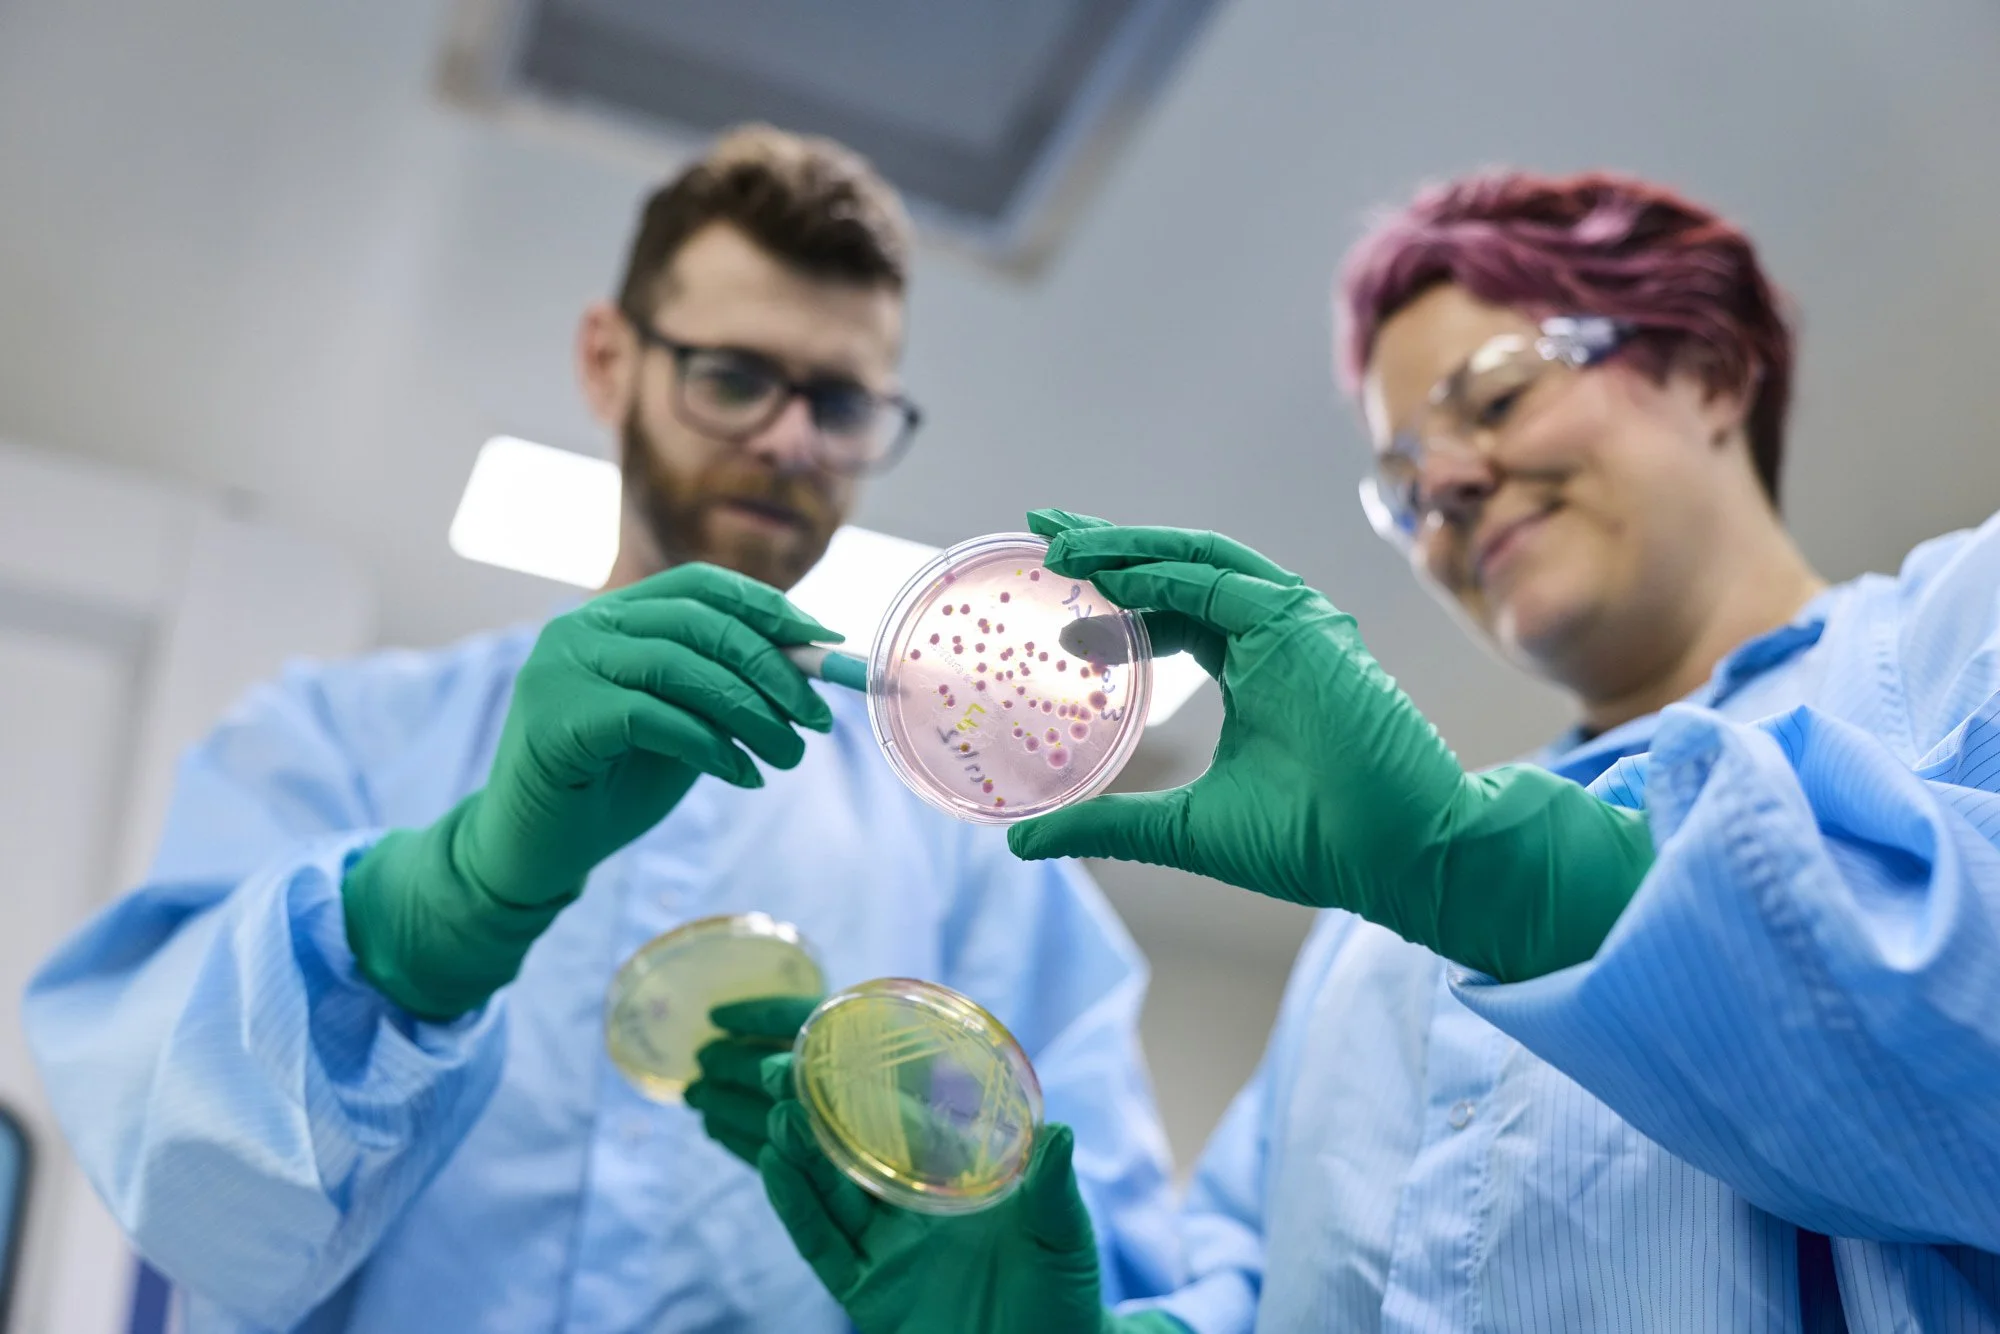

Australia's Sterile Manufacturing Solution
Pure Solutions is a GMP-licensed Australian contract manufacturer specialising in aseptic fill-finish for small batches of liquid medicines and high quality microbiological testing services. We partner with pharmaceutical, biotech, and healthcare organisations to deliver pure, reliable, flexible and compliant solutions that support product development and clinical success.






Meet our team
-

Justine Mann
MBA, BAppSc
CHIEF EXECUTIVE OFFICER -

Nigel Baade
BCom, CPA, MAICD
CHIEF FINANCIAL OFFICER -

Catherine Osborne
PhD, GAICD
BUSINESS DEVELOPMENT DIRECTOR -

Robyn Hofer
BASci
MICROBIOLOGY & STERILITY ASSURANCE MANAGER -

Andrew Hoxey
BAppSc, MSc
QUALITY MANAGER -

Carlo Volpe
PhD
PRODUCTION MANAGER


Our mission
“We created Pure Solutions to redefine what ‘pure’ really means: custom-built precision, reliable quality and streamlined operations. Combining our state-of-the-art facilities with unmatched expertise, we deliver results that our clients can trust, every time.”








News
Download the Sample Analysis Form to submit your analysis request